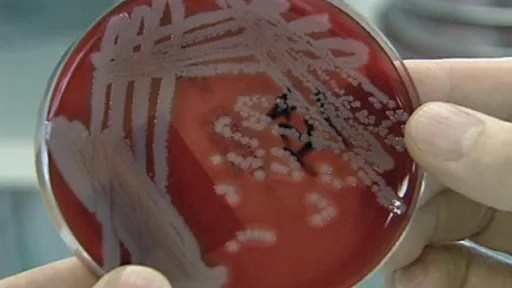

Medicii sunt în stare de alertă, întrucât s-a dovedit că bacteria este rezistentă la toate antibioticele, inclusiv la cele de ultimă instanţă, pe care specialiştii le folosesc numai în cazurile când alte antibiotice nu dau rezultate.
Într-un raport publicat joi de Ministerul American al Apărării, bacteria foarte rezistentă a fost identificată în urina unei femei în vârstă de 49 de ani din Pennsylvania, SUA, de către Centrul Medical Militar Naţional Walter Reed.Este vorba de o formă rară de infecţie cu bacteria E. coli, rezistentă la antibiotice, chiar şi la Colistin, preparat pe care medicii în SUA îl folosesc uneori ca antibiotic de rezervă, relatează CNN.În acest moment nu sunt disponibile date în legătură cu modul în care femeia a fost infectată, se ştie doar că ea nu a călătorit în afara Statelor Unite, în ultimele cinci luni.Această bacterie a fost identificată şi la pacienţi din afara Statelor Unite - în Europa, Canada şi China, iar cazurile de infecţii cu bacterii super-rezistente sunt în creştere. Un raport sugerează că acest tip de infecţie poate duce la moartea a jumătate dintre pacienţii infectaţi.Rezistenţa la antibiotice a devenit o problemă tot mai mare şi Organizatia Mondiala a Sănătăţii a avertizat că aceasta este una dintre cele mai mari ameninţări la adresa sănătăţii la nivel mondial în prezent.Expertul Dr. Tom Frieden, a avertizat că, deşi acesta este primul caz în Statele Unite, este de aşteptat să apară mai multe cazuri de infecţii cu astfel de super-bacterii în viitorul apropiat. Frieden, care îi avertizează de multe ori pe medici împotriva utilizării excesice de antibiotice, a sugerat oamenilor de ştiinţă să dezvolte rapid noi medicamente.În contextul publicării acestui caz în Statele Unite, Marea Britanie a cerut vineri la Tokyo, unde se desfăşoară summitul G7, ca ţările membre să faca mai mult pentru a lupta împotriva acestor super-bacterii ucigaşe. Premierul britanic, David Cameron, a afirmat că ţările cele mai dezvoltate trebuie să abordeze rezistenţa la antibiotice prin reducerea utilizării acestora şi prin recompensarea companiilor de profil pentru dezvoltarea de noi medicamente, relateaza Reuters.[blockquote-quoted]„In prea multe cazuri, antibioticele au încetat să funcţioneze. Asta înseamnă că oamenii mor de infectii simple sau boli precum tuberculoza, tetanos, sepsii şi alte infecţii care nu ar trebui să însemne o condamnare la moarte”, a declarat el la o conferinţă de presa la summitul ce se desfasoară în Japonia.[/blockquote-quoted][blockquote-quoted]„Dacă nu vom acţiona, vom asista la un scenariu aproape de neconceput în care antibioticele nu mai functionează şi suntem aruncati inapoi in veacurile intunecate ale medicinei, cand infectii si leziuni ce pot fi tratate vor ucide din nou. Pur si simplu nu se poate permite sa se intample acest lucru si vreau sa vad un raspuns global mai coerent si mai puternic”, a mai spus premierul.[/blockquote-quoted]Potrivit The Guardian, el a promis ca Marea Britanie va conduce un efort global pentru dezvoltarea de noi medicamente.